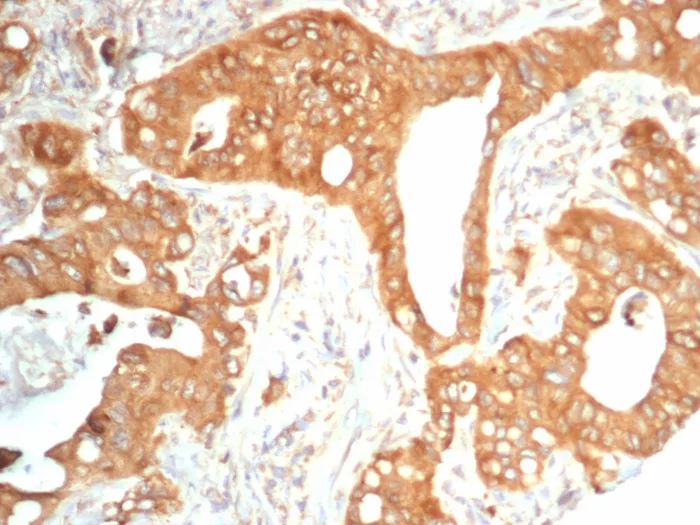
Formalin-fixed, paraffin-embedded human colon carcinoma stained with NTRK2 / TRKb Mouse Monoclonal Antibody (NTRK2/4673). HIER: Tris/EDTA, pH9.0, 45min. 2°C: HRP-polymer, 30min. DAB, 5min. NTRK2 (Neurotrophic Receptor Tyrosine Kinase 2) Antibody - Image 2

Formalin-fixed, paraffin-embedded human lung carcinoma stained with NTRK2 / TRKb Mouse Monoclonal Antibody (NTRK2/4673). HIER: Tris/EDTA, pH9.0, 45min. 2°C: HRP-polymer, 30min. DAB, 5min.
Formalin-fixed, paraffin-embedded human colon carcinoma stained with NTRK2 / TRKb Mouse Monoclonal Antibody (NTRK2/4673). HIER: Tris/EDTA, pH9.0, 45min. 2°C: HRP-polymer, 30min. DAB, 5min.

Analysis of Protein Array containing more than 19,000 full-length human proteins using NTRK2 / TRKb Mouse Monoclonal Antibody (NTRK2/4673). Z- and S- Score: The Z-score represents the strength of a signal that a monoclonal antibody (MAb) (in combination with a fluorescently-tagged anti-IgG secondary antibody) produces when binding to a particular protein on the HuProtTM array. Z-scores are described in units of standard deviations (SD's) above the mean value of all signals generated on that array. If targets on HuProtTM are arranged in descending order of the Z-score, the S-score is the difference (also in units of SD's) between the Z-score. S-score therefore represents the relative target specificity of a MAb to its intended target. A MAb is considered to specific to its intended target, if the MAb has an S-score of at least 2.5. For example, if a MAb binds to protein X with a Z-score of 43 and to protein Y with a Z-score of 14, then the S-score for the binding of that MAb to protein X is equal to 29.
The Trk proto-oncogene encodes a tyrosine protein kinase, Trk A, also designated Trk gp140, that serves as a receptor for certain neurotrophic factors including nerve growth factor (NGF) and neurotrophin-3 (NT-3). Trk B is a tyrosine kinase gene highly related to Trk A. Trk B expression is confined to tissues within the central and peripheral nervous systems. The brain-derived neurotrophic factor (BDNF) and NT-3, but not NGF, can induce rapid phosphorylation on tyrosine of Trk B gp145, one of the receptors encoded by NTRK2, although BDNF elicits a response at least two orders of magnitude greater than NT-3. Thus it appears that Trk B gp145 may represent a neurotrophic receptor for BDNF and NT-3. The third member of the Trk family of tyrosine kinases, Trk C, encodes a protein designated Trk C gp145 that is preferentially expressed in brain tissue, is equally related to Trk A and Trk B and is a functional receptor for NT-3.
There are no reviews yet.